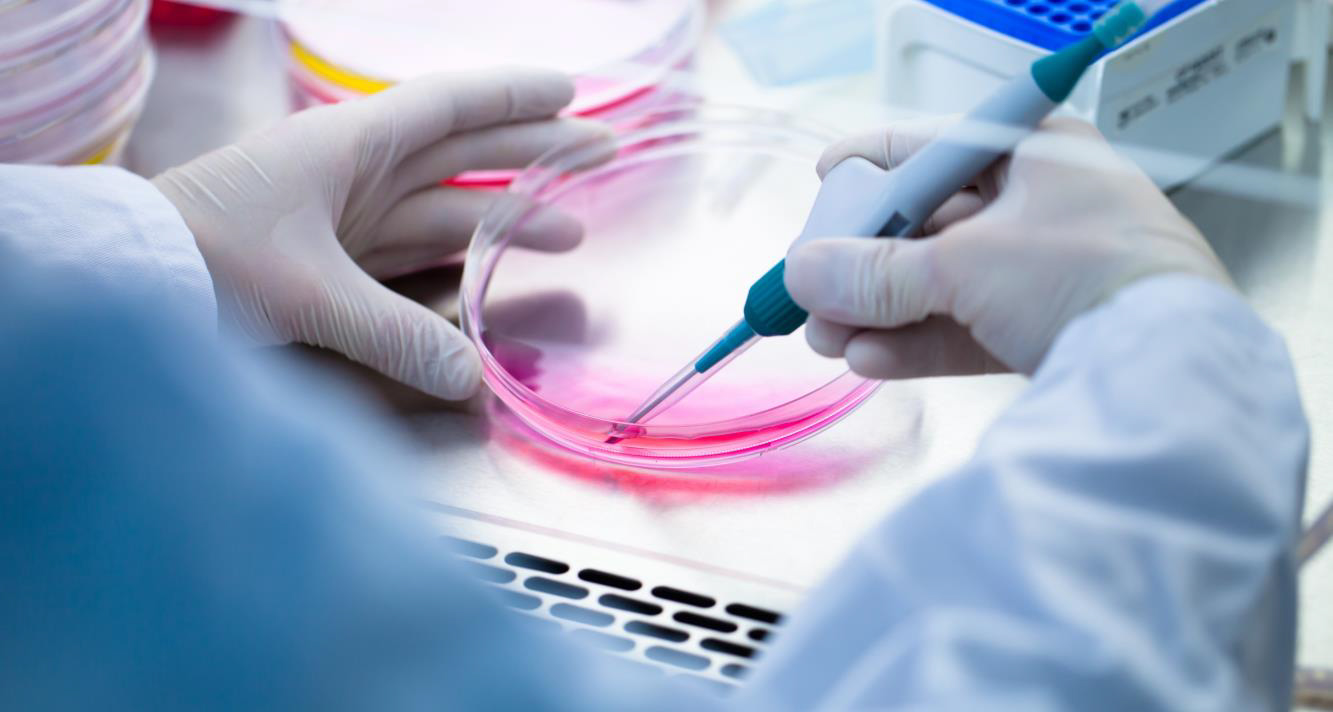
Life Science

Wings on Board: Delivering life-saving solutions where seconds matter
In the realm of life sciences, where medical breakthroughs and critical research hang in the balance, timely and secure delivery of sensitive specimens, pharmaceuticals, and research materials is essential. Wings on Board understands the gravity of these shipments and tailors its services to ensure life-saving solutions reach their destination quickly and safely.
Why Wings on Board is your life science partner:
- Unwavering Speed: We prioritize rapid response and secure transport, hand-carry services with dedicated couriers utilizing methods like temperature-controlled containers to ensure deliveries meet strict time and temperature requirements.
- Regulatory Experts: Our team possesses the knowledge of complex life science regulations and compliance needs, ensuring smooth customs clearance and adherence to international standards.
- Global Reach, Local Touch: With extensive partnerships and operations worldwide, Wings on Board delivers critical life science shipments to laboratories, hospitals, and research facilities anywhere on the globe, regardless of remote locations or stringent protocols.
- Safety First: We employ robust security protocols and chain-of-custody procedures to guarantee the integrity and safety of your sensitive shipments, mitigating risks and ensuring samples arrive uncompromised.

Trust Wings on Board to:
- Accelerate Research: Get time-sensitive materials to researchers faster, accelerating life-saving breakthroughs and advancements.
- Ensure Patient Care: Deliver critical medical supplies and pharmaceuticals swiftly, improving patient outcomes and reducing wait times.
- Navigate Regulations with Confidence: Rely on our expertise to navigate complex regulatory landscapes and ensure seamless international shipments.
- Minimize Risk, Maximize Impact: Secure the integrity and safety of your valuable specimens and research materials, ensuring your work has the desired impact.